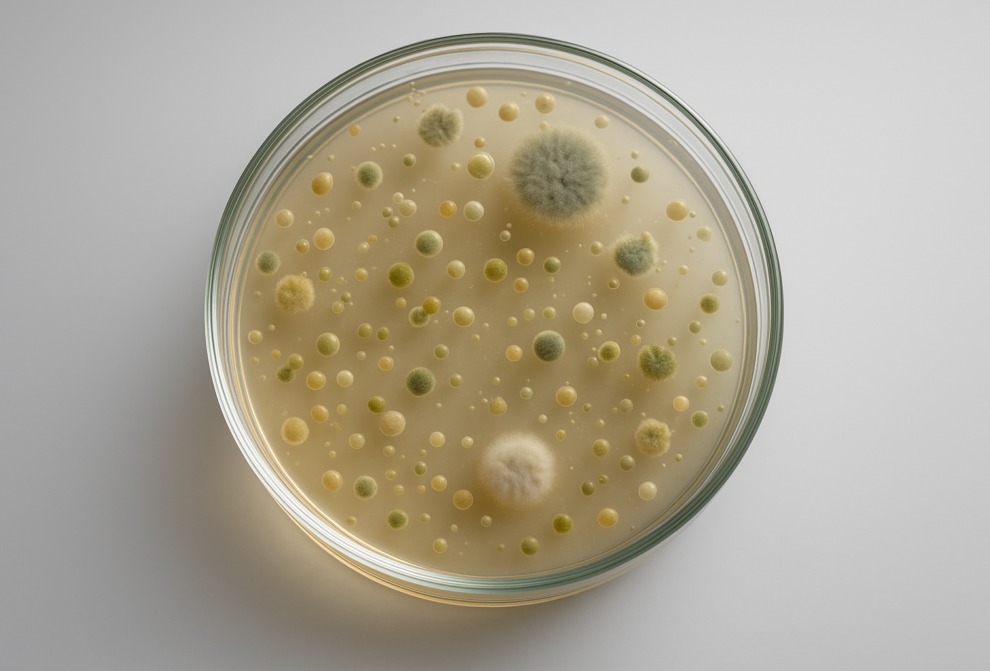
AI Generated Image

Mikroorganismen Für Nachhaltigen Strukturwandel Nutzen
AI Generated Image
Ministerpräsident Alexander Schweitzer informierte sich am Campus Pirmasens der Hochschule Kaiserslautern über das Leuchtturmprojekt „Waste2Value – Mikroorganismen verändern die Westpfalz“.
Der Ministerpräsident von Rheinland-Pfalz, Alexander Schweitzer, hat am Dienstag, den 12. August 2025, den Campus Pirmasens der Hochschule Kaiserslautern besucht, um sich über das vom Bundesministerium für Forschung, Technologie und Raumfahrt geförderte Forschungsbündnis „Waste2Value – Mikroorganismen verändern die Westpfalz“ zu informieren. Im Rahmen einer kompakten Veranstaltung erhielten der Ministerpräsident und geladene Gäste Einblicke in das interdisziplinäre Projekt, das sich zu einem Vorzeigevorhaben im Bereich der Weißen Biotechnologie in Rheinland-Pfalz entwickelt hat.
Im Mittelpunkt des Besuchs stand die Vorstellung des interdisziplinären Bündnisses Waste2Value, das Reststoffe aus Landwirtschaft, Lebensmittelproduktion und Industrie mithilfe von Mikroorganismen in wertvolle Chemikalien und Materialien umwandelt – darunter biobasierte Kunststoffe, Extrakte für Kosmetik und Nahrungsmittel sowie innovative Werkstoffverbunde. Dabei kommen Bakterien und Mikroalgen zum Einsatz, deren stoffliche Fähigkeiten gezielt in biotechnologischen Prozessen genutzt werden. Das Projekt verfolgt einen ganzheitlichen Ansatz, um regionale Ressourcen zu nutzen, neue Wertschöpfungsketten zu etablieren und damit aktiv zum Strukturwandel in der Westpfalz beizutragen.
Die Hochschule Kaiserslautern übernimmt gemeinsam mit dem Prüf- und Forschungsinstitut Pirmasens (PFI) sowie der ZukunftsRegion Westpfalz (ZRW) die koordinierende Rolle im Bündnis. Bereits in der ersten Umsetzungsphase wurden rund 10 Millionen Euro in 15 Projekte investiert – mit Beteiligung von über 40 regionalen Unternehmen. In der kommenden Projektphase, die mit weiteren 5,2 Millionen Euro finanziert wird, liegt der Schwerpunkt auf der Weiterentwicklung vielversprechender biotechnologischer Verfahren im Demonstrationsmaßstab, um die industrielle Anwendbarkeit zu erproben.
Die Veranstaltung begann mit einer Begrüßung durch Prof. Dr. Peter Starke, Vizepräsident für Forschung und Transfer, der die Hochschulleitung vertrat, gefolgt von einem Grußwort von Ministerpräsident Schweitzer, in dem er das Projekt als „herausragendes Beispiel für nachhaltige Innovationskraft in der Westpfalz“ würdigte. Anschließend stellten Dr. Michael Lakatos (Bündnisleiter, Hochschule Kaiserslautern) und Dr. Stefan Dröge (PFI) das Projekt „Waste2Value“ sowie ausgewählte Innovationspfade vor. Bei einem Rundgang durch das Biotechnikum des PFI sowie das Algentechnikum der Hochschule erhielten die Teilnehmenden konkrete Einblicke in die Forschungspraxis – von der mikrobiellen Reststoffumwandlung bis zur Produktion wertvoller Zusatzstoffe für Lebensmittel durch Cyanobakterien.
Das Bündnis „Waste2Value“ steht für eine Verknüpfung traditioneller Kompetenzen aus der Schuh- und Textilindustrie mit moderner Bioverfahrenstechnik. Die entwickelten Verfahren zielen auf nachhaltige Kreislaufwirtschaft, wirtschaftliche Konkurrenzfähigkeit und CO₂-Einsparungen ab. Sie können einen zentralen Beitrag leisten, um langfristig rund ein Viertel der in Deutschland benötigten Kunststoffe biobasiert herzustellen und bis zu 8 Millionen Tonnen CO2 einzusparen.
Ministerpräsident Alexander Schweitzer würdigte im Rahmen seines Besuchs am Campus Pirmasens nicht nur die wissenschaftlichen Leistungen des Bündnisses „Waste2Value“, sondern zeigte sich auch beeindruckt vom Engagement, dem Pioniergeist und der Innovationskraft der Region. Er betonte die zentrale Bedeutung solcher Projekte für den klimaschonenden Umbau der Wirtschaft und die Stärkung strukturschwächerer Regionen. „Aus Abfall Wert zu schaffen – das ist eine Vision, die mit Waste2Value in greifbare Nähe rückt.“
Weitere Informationen unter https://w2v-rlp.de/
Contact for scientific information:
Dr. Michael Lakatos Tel: +49 (631) 3724 – 7032, mailto:michael.lakatos@hs-kl.de
Quelle: IDW-Online









